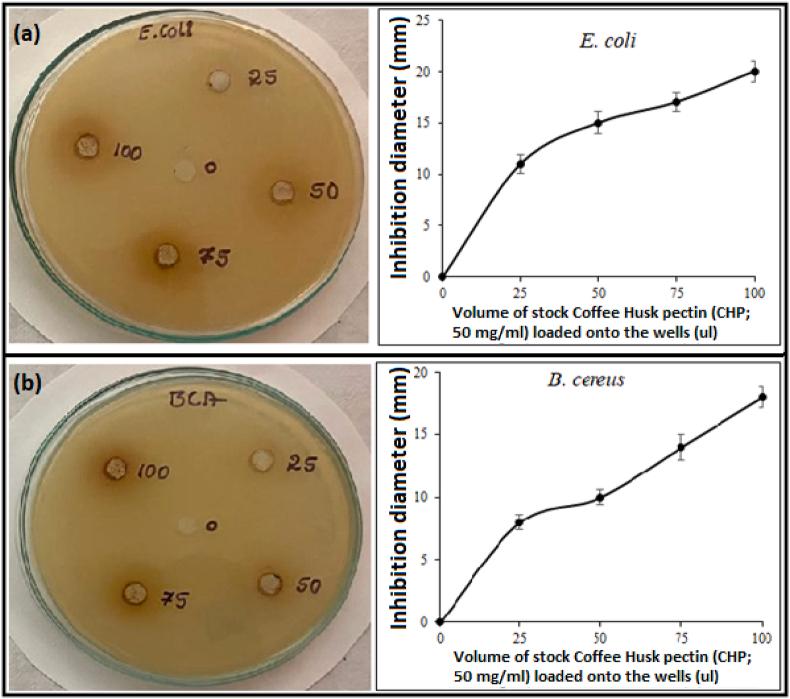
https://cdn.ncbi.nlm.nih.gov/pmc/blobs/3ce5/10559994/492fd4085129/gr9.jpg

咖啡豆加工废料的价值化利用以可持续提取生物活性果胶
Valorization of coffee bean processing waste for the sustainable extraction of biologically active pectin.
作者信息
Divyashri Gangaraju, Krishna Murthy Thirupathihalli Pandurangappa, Ragavan Krishnamoorthy Vasanth, Sumukh Gangadhar Mugulurmutt, Sudha Lingam Sadananda, Nishka Srikanth, Himanshi Gupta, Misriya Nafisa, Sharada Bannappa, Anjanapura Venkataramanaiah Raghu
机构信息
Department of Biotechnology, M S Ramaiah Institute of Technology, Bengaluru, 560 054, Karnataka, India.
CSIR-National Institute for Interdisciplinary Science and Technology, Thiruvananthapuram, 695 019, Kerala, India.
出版信息
Heliyon. 2023 Sep 17;9(9):e20212. doi: 10.1016/j.heliyon.2023.e20212. eCollection 2023 Sep.
The dry method of coffee processing generates a significant amount of coffee husk, an agricultural waste for which currently there is a lack of profitable use, and their disposal constitutes a major environmental problem. Pectin was extracted from coffee husk using citric acid solution (pH 1.5) by microwave-assisted extraction method, followed by using ice-cold ethanol. The coffee husk pectin (CHP) with a yield of 40.2% was characterized using SEM, FT-IR, and XRD techniques. The CHP exhibited significant antioxidant activity as measured by using 2,2-diphenyl-1-picrylhydrazyl; (IC value of 395.1 ± 0.42 μg/mL), ferrous reducing antioxidant capacity (A = 0.55 ± 0.08), 2,2'-Azino-bis (3-ethylbenzothiazoline-6-sulfonic acid) radical scavenging (42.02 ± 0.38%) and ascorbic acid auto-oxidation inhibition (92.01 ± 0.28%) assays. CHP demonstrated antibacterial activity against and with an inhibition diameter of 20 ± 1.01 mm and 18 ± 0.84 mm, respectively. Interestingly, CHP showed a significant anti-inflammatory effect by negatively modulating the expressions of TNF-α and TGF- β in LPS-stimulated macrophage cell lines. Collectively, our findings suggest that the coffee husk is a potential source of commercial pectin, microwave-assisted extraction has a great potency on the commercial pectin extraction from the coffee husk and CHP demonstrates significant biological activity.
咖啡加工的干法会产生大量咖啡壳,这是一种农业废弃物,目前缺乏有利可图的用途,其处置构成了一个重大的环境问题。采用微波辅助萃取法,用柠檬酸溶液(pH 1.5)从咖啡壳中提取果胶,然后使用冰冷乙醇。采用扫描电子显微镜(SEM)、傅里叶变换红外光谱(FT-IR)和X射线衍射(XRD)技术对产率为40.2%的咖啡壳果胶(CHP)进行了表征。通过2,2-二苯基-1-苦基肼自由基清除法(IC值为395.1±0.42μg/mL)、亚铁还原抗氧化能力法(A=0.55±0.08)、2,2'-联氮-双-(3-乙基苯并噻唑啉-6-磺酸)自由基清除法(42.02±0.38%)和抗坏血酸自氧化抑制法(92.01±0.28%)测定,CHP表现出显著的抗氧化活性。CHP对金黄色葡萄球菌和大肠杆菌表现出抗菌活性,抑菌直径分别为20±1.01mm和18±0.84mm。有趣的是,CHP通过负向调节脂多糖刺激的巨噬细胞系中肿瘤坏死因子-α(TNF-α)和转化生长因子-β(TGF-β)的表达,显示出显著的抗炎作用。总的来说,我们的研究结果表明,咖啡壳是商业果胶的潜在来源,微波辅助萃取对从咖啡壳中提取商业果胶具有很大潜力,并且CHP表现出显著的生物活性。